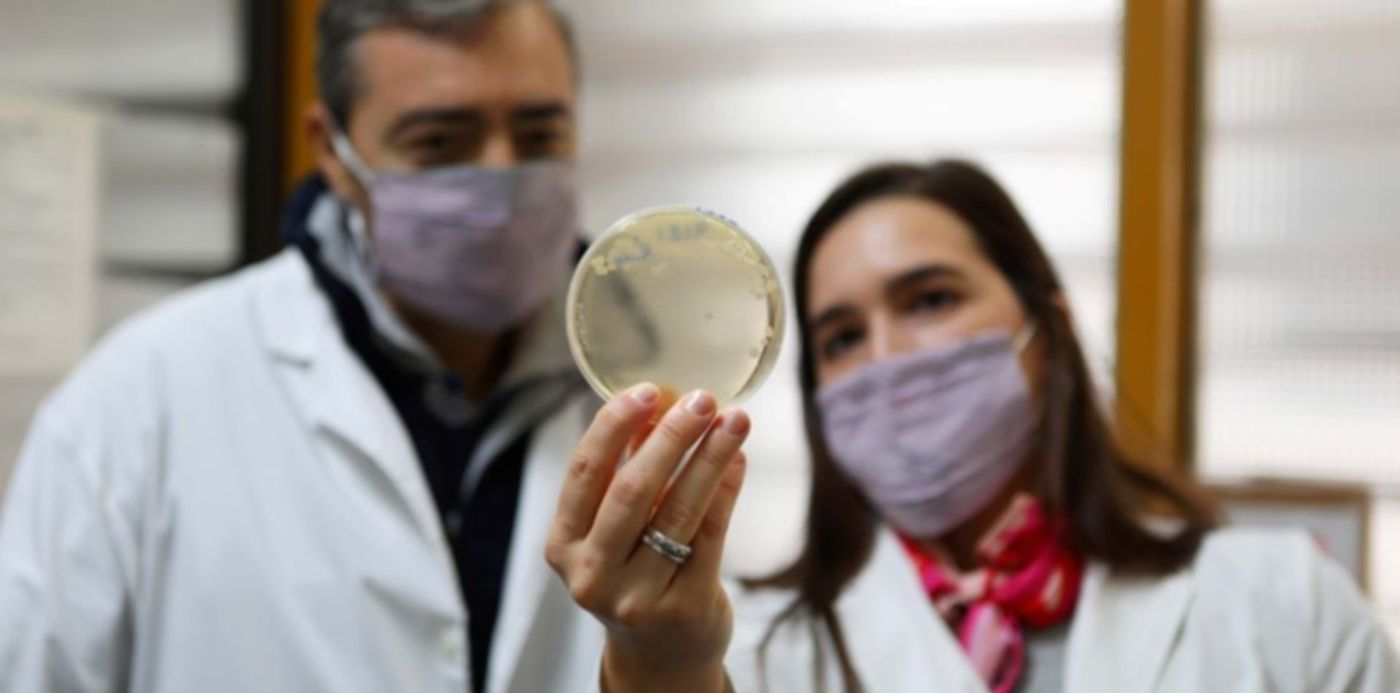
conicet

Investigadores del CONICET buscan convertir los lactosueros, desechos de la industria láctea; en biocombustibles, proteínas y probióticos. La iniciativa, que avanza sin contratiempos en La Plata, se desarrolla en el marco de un proyecto financiado por el Gobierno nacional que promueve la vinculación del sector científico con el productivo, informó el organismo científico.
Se trata de la "Valorización del lactosuero para producción de concentrado proteico, bioetanol y biomasa probiótica. Validación de propiedades probióticas de Kluyveromyces marxianus obtenido en escala piloto", que fue presentado por el investigador Martín Rumbo, director del Instituto de Estudios Inmunológicos y Fisiopatológicos (IIFP, CONICET-UNLP).
El proyecto propone reutilizar el lactosuero, remanente de la producción de quesos, como materia prima para la obtención de bioetanol –de potencial uso como combustible ecológico–, proteínas y levaduras probióticas, gracias a las propiedades de la levadura Kluyveromyces marxianus, de excelente capacidad para ser empleada en la fermentación de ese suero, según se informó en un comunicado.
Este es uno de los proyectos que fueron seleccionados por el Ministerio de Ciencia, Tecnología e Innovación de la Nación (MINCyT), en el marco de la convocatoria denominada PICT Orientación a la Vinculación, a la que se destinarán más de 960 millones de pesos con el objetivo de fomentar la vinculación entre grupos de investigación científica y empresas o instituciones "adoptantes" del sector productivo para obtener resultados innovadores en áreas como la salud, la producción de alimentos con valor agregado, producción "verde" y tecnologías asociadas a la transformación digital.
"Algunas de sus cepas alcanzan una eficiencia mayor al 90% en la transformación de lactosa en bioetanol. Asimismo, tras ese proceso mantiene sus propiedades probióticas: en las pruebas in vitro vimos que tiene la capacidad de sobrevivir al paso por el tracto gastrointestinal y de modular la respuesta inmune innata del epitelio intestinal; y, además, en un modelo animal, una de las cepas más eficientes para la fermentación permitió proteger contra el daño causado por colitis aguda. Es decir, el excedente de biomasa de levadura obtenido puede ser potencialmente comercializado como probiótico", explicaron los miembros del equipo de expertos que trabaja en la iniciativa.

La próxima etapa del proyecto –que recibió un subsidio de 40 millones de pesos– consiste en el aumento de la escala productiva para obtener mayor cantidad de levaduras a partir del lactosuero y probar sus capacidades probióticas en modelos de laboratorio y también en animales de producción, particularmente en pollos, como suplemento alimenticio para las primeras semanas de edad.
"En general, en pollos de cría se están usando como promotores de crecimiento muchos antibióticos que cambian la ecología intestinal y, si bien favorecen el uso de la energía de los alimentos para crecimiento, generan mucha resistencia a esos antibióticos, sin tratar infecciones específicas. Lo que proponemos es estudiar la capacidad antiinflamatoria de nuestra levadura, K marxianus, para reemplazar con ella el uso de los antibióticos como promotores de crecimiento", comentó Rumbo.

Del proyecto participan expertos y expertas del Centro de Investigación y Desarrollo en Criotecnología de Alimentos (Cidca-Conicet-UNLP), el Centro de Investigación y Desarrollo en Fermentaciones Industriales (Cindefi-Conicet-UNLP) y el Instituto Nacional de Tecnología Agropecuaria (INTA Castelar). "La empresa adoptante, Beneficial Germs S.A., está dedicada a la producción de microorganismos para aplicación en alimentación animal, y su aporte será llevar el escalado productivo a nivel industrial. Además, en caso de poder desarrollarse con éxito, ellos serán los usuarios de la tecnología, ya que el objetivo es hacerla llegar del laboratorio a la industria", destacó el científico